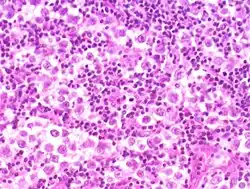

Seminom
| Klassifikation nach ICD-10 | |
|---|---|
| C62 | Bösartige Neubildung des Hodens |
| ICD-10 online (WHO-Version 2019) | |

Bei einem Seminom (von lateinisch semen „Samen“) handelt es sich um einen bösartigen Keimzelltumor des Hodens, der seinen Ursprung in der Entartung von Spermatogonien (Keimgewebe) hat.
Das Seminom tritt etwas später – durchschnittlich bei 37-jährigen Männern – als das Nichtseminom auf.[1] Typisches Frühsymptom ist die schmerzlose Schwellung meist eines Hodens.
Behandlung
Die Behandlung geschieht stadiengerecht.[2] In frühen Stadien liegt das Risiko für eine okkulte Metastasierung (also eine Metastasierung, die trotz regelgerechter Staging-Untersuchung noch nicht erkennbar ist) in die regionären Lymphknoten bei etwa 20 %; das heißt bei einem von fünf Patienten, die nicht weiter therapiert wurden, kommt es zu einem erneuten Auftreten der Erkrankung in den Lymphknoten im Bauchraum. Seminome, die kleiner als 4 cm sind und keine Infiltration des umliegenden Gewebes zeigen, weisen ein geringeres Metastasierungsrisiko auf. Nach der Orchiektomie kann daher entweder abgewartet und engmaschig kontrolliert werden (Wait and see) und beim Wiederauftreten der Erkrankung bestrahlt oder chemotherapiert werden. Da durch die Bestrahlung das Risiko für weitere Krebserkrankungen besteht, wird darauf mittlerweile bei leichten Stadien (IA oder IB) in der Regel verzichtet. Weitere Maßnahmen neben der Wait-and-see-Methode sind eine Chemotherapie mit dem Mittel Carboplatin bei Stadium IA und IB. In anderen Stadien werden andere Medikamente verwendet oder eine Strahlentherapie durchgeführt. Mittlerweile wird die Chemotherapie mit Carboplatin auch nur noch bei Risikopatienten angewendet. Die Chemotherapie senkt das Rezidivrisiko dabei auf etwa 5 % und wird in der Regel gut vertragen.
Als weitere Nachsorgemaßnahmen werden in unterschiedlichen Abständen ein Abdomen-MRT und eine Röntgenaufnahme des Thorax (Brustkorb) in zwei Ebenen empfohlen.[3]
Siehe auch
Einzelnachweise
- ↑ med. Dirk Manski: Hodentumor (Keimzelltumoren). In: urologielehrbuch.de. 14. November 2007, abgerufen am 22. November 2015.
- ↑ med. Dirk Manski: Therapie der Hodentumoren: Seminome und allgemeine Therapieprinzipien. In: urologielehrbuch.de. Abgerufen am 22. November 2015.
- ↑ Nachsorgeempfehlungen - Kurzübersicht. (PDF) Interdisziplinäre Arbeitsgruppe Hodentumore, archiviert vom (nicht mehr online verfügbar) am 4. März 2016; abgerufen am 22. November 2015. Info: Der Archivlink wurde automatisch eingesetzt und noch nicht geprüft. Bitte prüfe Original- und Archivlink gemäß Anleitung und entferne dann diesen Hinweis.